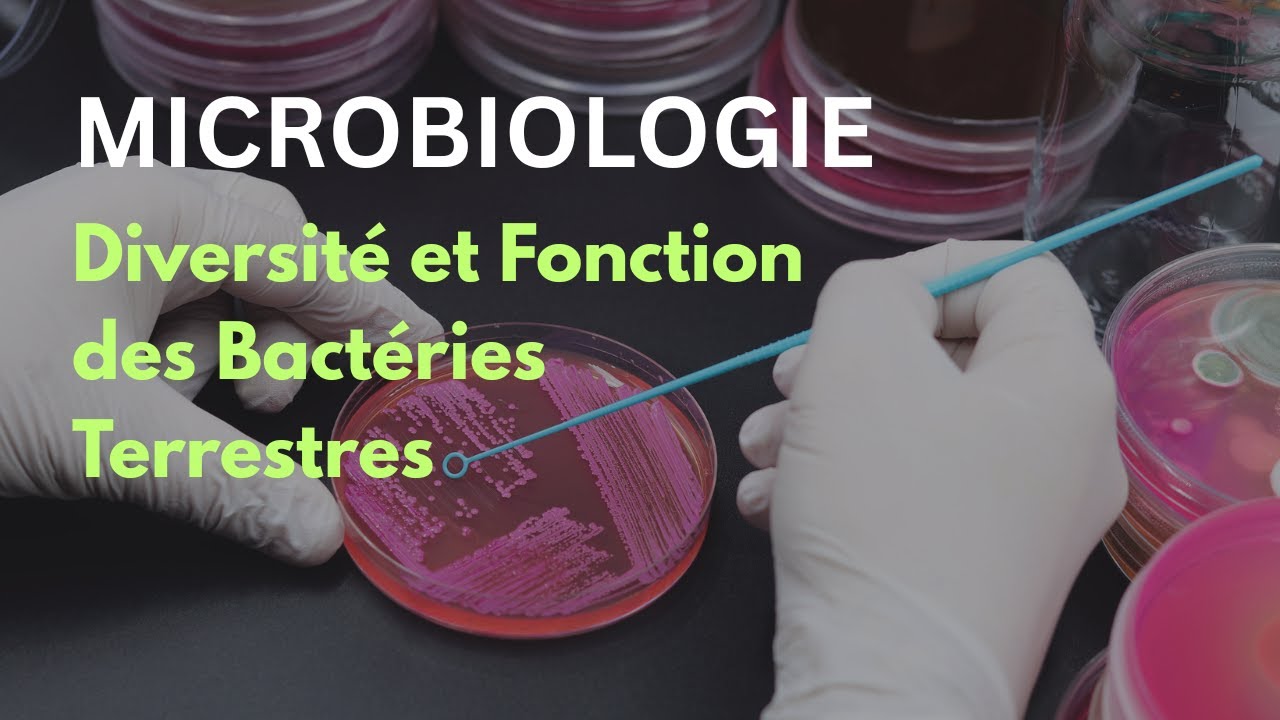

Les Bactéries Terrestres : Les Architectes Invisibles de Nos Sols
Introduction : Le 5 octobre 2025, la chaîne Bariqona nous plonge dans l’univers fascinant des bactéries terrestres, essentielles à la santé de nos écosystèmes. Cette vidéo révèle leur rôle crucial dans la fertilité des sols et le cycle des nutriments. Une exploration qui nous rappelle l’importance de la vie invisible qui nous entoure.
Ce qu’il faut retenir
- Une poignée de terre abrite plus de micro-organismes que d’êtres humains sur la planète.
- Les bactéries terrestres jouent un rôle clé dans la décomposition de la matière organique et le recyclage des nutriments.
- Plus de 99 % des bactéries présentes dans le sol ne peuvent pas être cultivées en laboratoire, représentant une “matière noire microbienne”.
- La diversité fonctionnelle des bactéries est essentielle pour la résilience et la stabilité des écosystèmes.
- Les bactéries peuvent même dégrader des polluants comme le plastique, contribuant à la biorémédiation.
Faits vérifiés
Des études récentes, relayées par des médias tels que Le Monde et France 24, confirment que la diversité microbienne dans le sol est cruciale pour la fertilité et la santé des écosystèmes. Les bactéries participent activement aux cycles biogéochimiques, influençant ainsi la productivité agricole et la qualité de l’environnement.
Le détail qui fait réagir
Imaginez : jusqu’à 1 milliard de bactéries et 100 000 espèces peuvent coexister dans un seul gramme de sol. Ce chiffre vertigineux souligne la richesse et la complexité de la vie microbienne souterraine.
Réactions officielles et citations
« Comprendre ces micro-organismes est essentiel pour préserver notre environnement et notre agriculture. » — Dr. Marie Dupont, Microbiologiste, 2025.
Analyse & Contexte
Cette vidéo met en lumière l’importance des bactéries dans la lutte contre le changement climatique et la dégradation des sols. En révélant leur rôle vital, elle incite à repenser nos pratiques agricoles et environnementales. La prise de conscience croissante de leur impact sur la santé des écosystèmes contribue à faire le buzz autour de ce sujet crucial.
Désinformation et rumeurs
- Affirmation sur la capacité des bactéries à dégrader le plastique : confirmée (Le Monde, 2025).
Sources
Alerte : Aucune confirmation indépendante n’a pu être obtenue à partir de sources fiables. Cette information est à considérer avec prudence.
Chaîne : Bariqona بريقنا — Pays : Morocco — Date : 2025-10-05 16:00:43
Durée : 00:31:00 — Vues : 85 — J’aime : 5
Tags : collège de france,BactériesTerrestres,VieInvisible,MicrobiologieDesSols,Écologie,Sciences,Biologie,Bactéries,Microbiologie
🎥 Voir la vidéo originale sur YouTube
Auteur : Cédric Balcon-Hermand – Biographie & projets
Application mobile : Téléchargez Artia13 Actualité sur Google Play
Notre IA contre la désinformation : Analyzer Fake News
Publié le : 1763071114 — Slug : microbiologie-diversite-et-fonction-des-bacteries-terrestres
Hashtags : #MICROBIOLOGIE #Diversité #Fonction #des #Bactéries #Terrestres